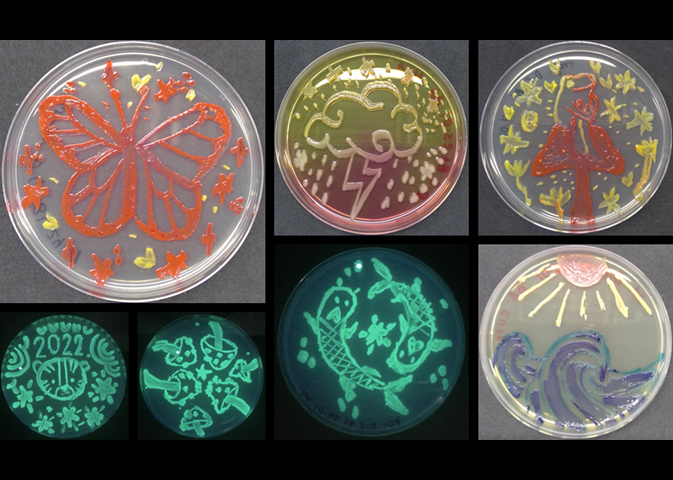
Jody Winter tweet media

@MelMLacey @omicsgoodman @DrWattret @sm_rutherford It was fab to meet you all and join the community. Great talks, great venue and food. Thank you for splendid hosting. Looking forward to next year.
English
Karin Garrie
3 posts



Lots of fun to visit @TrentUni to hear about the work @ian_c_whittaker has been doing to bring Science & Technology students together with a series of talks inspired by the Lunar New Year. Also got a bit creative (!) in a lantern making workshop. To be continued #WatchThisSpace